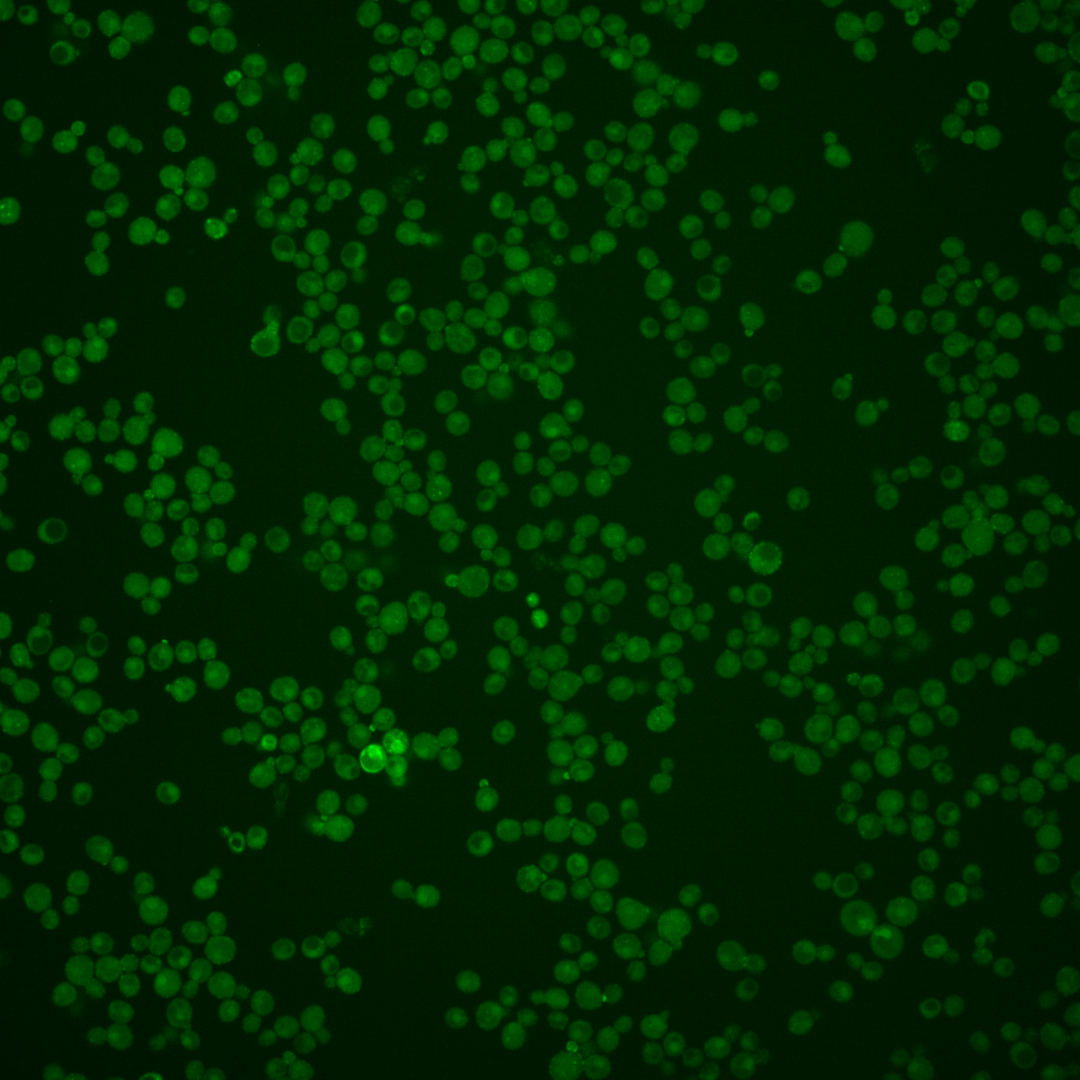
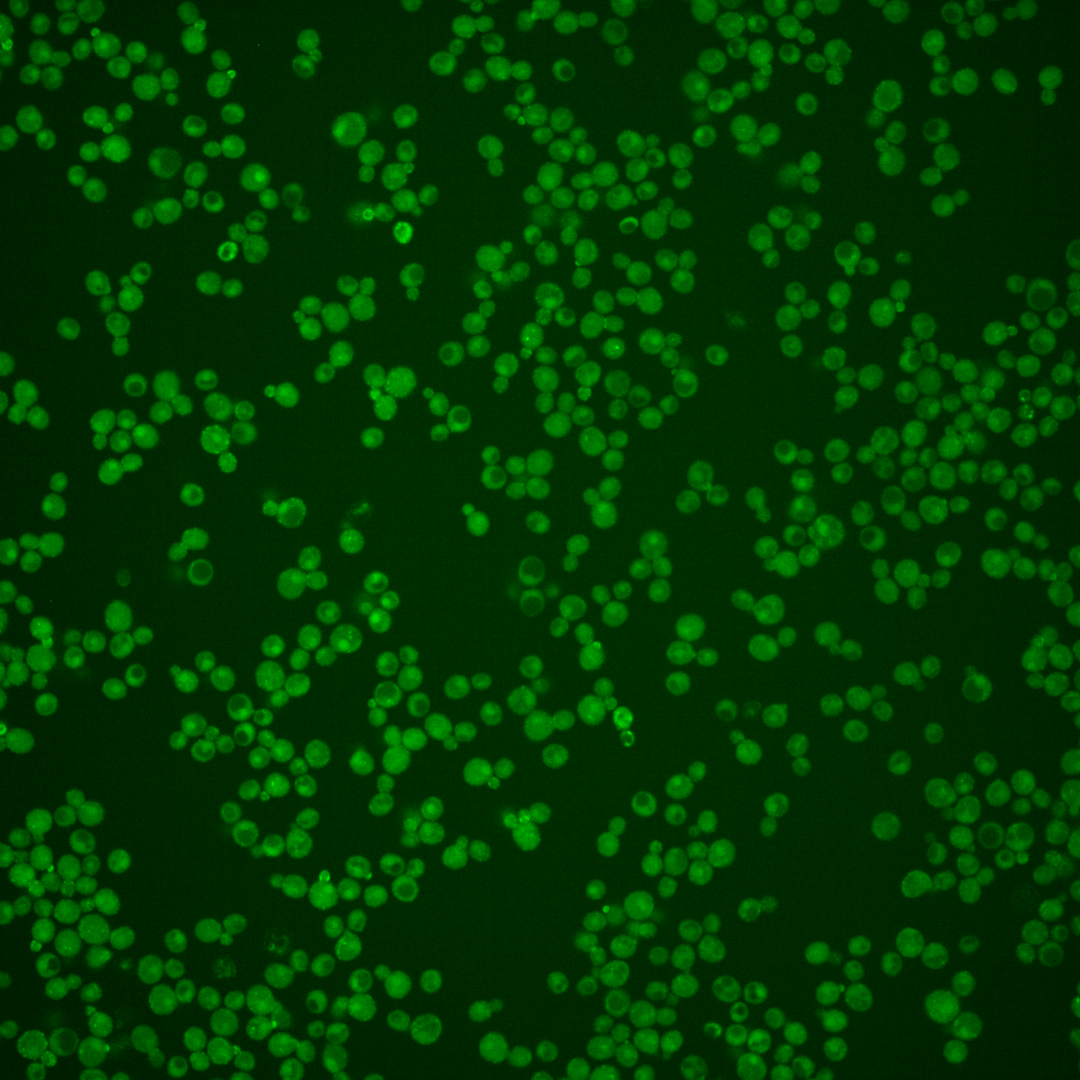

| Standard name | |
|---|---|
| Human Ortholog | |
| Description | Mannoprotein that exhibits a tight association with the cell wall; required for cell wall stability in the absence of GPI-anchored mannoproteins; has a high serine-threonine content; expression is induced in cell wall mutants; SRL1 has a paralog, SVS1, that arose from the whole genome duplication |
Micrographs




















































































Sub-cellular Localization
Yeast GFP Assignment
Protein Abundance
Localization Change
External localization resources
| ensLOC | DeepLoc | |||||||||||||||||||||||
|---|---|---|---|---|---|---|---|---|---|---|---|---|---|---|---|---|---|---|---|---|---|---|---|---|
| Localization | WT1 | WT2 | WT3 | RAP60 | RAP140 | RAP220 | RAP300 | RAP380 | RAP460 | RAP540 | RAP620 | RAP700 | HU80 | HU120 | HU160 | rpd3Δ_1 | rpd3Δ_2 | rpd3Δ_3 | WT1 | WT2 | WT3 | AF100 | AF140 | AF180 |
| Cortical Patches | 8 | 8 | 1 | 2 | 4 | 4 | 15 | – | 2 | 11 | 14 | 8 | 10 | 32 | 26 | 8 | 0 | 2 | 18 | 9 | 7 | 24 | 35 | 30 |
| Bud | 3 | 3 | 0 | 3 | 0 | 12 | 9 | – | 7 | 14 | 30 | 39 | 3 | 15 | 5 | 2 | 0 | 0 | 9 | 6 | 5 | 7 | 12 | 8 |
| Bud Neck | 0 | 1 | 4 | 2 | 1 | 0 | 2 | – | 0 | 4 | 3 | 3 | 0 | 1 | 0 | 0 | 0 | 1 | 13 | 15 | 12 | 13 | 24 | 18 |
| Bud Site | 0 | 2 | 0 | 0 | 0 | 0 | 1 | – | 1 | 0 | 2 | 0 | 0 | 3 | 0 | 1 | 0 | 0 | – | – | – | – | – | – |
| Cell Periphery | 1 | 1 | 1 | 7 | 2 | 4 | 14 | – | 2 | 9 | 8 | 10 | 10 | 18 | 22 | 6 | 0 | 0 | 1 | 2 | 4 | 5 | 11 | 12 |
| Cytoplasm | 182 | 87 | 136 | 199 | 249 | 224 | 359 | – | 184 | 267 | 418 | 537 | 87 | 233 | 234 | 198 | 157 | 99 | 32 | 21 | 15 | 30 | 55 | 70 |
| Endoplasmic Reticulum | 26 | 21 | 5 | 1 | 1 | 6 | 11 | – | 9 | 2 | 1 | 2 | 14 | 10 | 11 | 16 | 7 | 8 | 31 | 4 | 10 | 23 | 44 | 48 |
| Endosome | 21 | 0 | 0 | 1 | 3 | 1 | 3 | – | 0 | 1 | 1 | 2 | 1 | 15 | 10 | 9 | 0 | 2 | 15 | 0 | 3 | 3 | 2 | 3 |
| Golgi | 1 | 0 | 0 | 0 | 0 | 0 | 0 | – | 0 | 0 | 0 | 0 | 1 | 0 | 0 | 0 | 0 | 0 | 4 | 0 | 0 | 2 | 1 | 2 |
| Mitochondria | 3 | 2 | 0 | 0 | 0 | 3 | 6 | – | 9 | 10 | 25 | 25 | 0 | 1 | 0 | 6 | 0 | 3 | 15 | 6 | 10 | 11 | 8 | 10 |
| Nucleus | 3 | 1 | 1 | 1 | 0 | 3 | 3 | – | 3 | 2 | 4 | 6 | 0 | 1 | 0 | 12 | 6 | 9 | 0 | 0 | 0 | 0 | 0 | 0 |
| Nuclear Periphery | 0 | 0 | 0 | 0 | 0 | 0 | 1 | – | 0 | 0 | 1 | 1 | 0 | 2 | 0 | 0 | 0 | 0 | 0 | 0 | 0 | 0 | 0 | 0 |
| Nucleolus | 0 | 0 | 0 | 0 | 0 | 0 | 0 | – | 0 | 1 | 0 | 3 | 0 | 0 | 0 | 0 | 0 | 0 | 0 | 0 | 0 | 0 | 0 | 0 |
| Peroxisomes | 2 | 0 | 0 | 0 | 0 | 0 | 0 | – | 0 | 1 | 0 | 1 | 1 | 10 | 12 | 2 | 0 | 1 | 0 | 0 | 0 | 0 | 0 | 0 |
| SpindlePole | 2 | 0 | 2 | 2 | 2 | 1 | 5 | – | 0 | 5 | 5 | 4 | 2 | 16 | 15 | 8 | 0 | 2 | 0 | 0 | 0 | 0 | 1 | 2 |
| Vac/Vac Membrane | 69 | 7 | 11 | 10 | 36 | 6 | 27 | – | 3 | 7 | 12 | 20 | 1 | 3 | 5 | 93 | 32 | 40 | 207 | 77 | 120 | 97 | 125 | 100 |
| Unique Cell Count | 294 | 125 | 156 | 215 | 272 | 247 | 410 | 211 | 294 | 465 | 590 | 120 | 304 | 308 | 307 | 181 | 145 | 355 | 147 | 195 | 223 | 327 | 314 | |
| Labelled Cell Count | 321 | 133 | 161 | 228 | 298 | 264 | 456 | 220 | 334 | 524 | 661 | 130 | 360 | 340 | 361 | 202 | 167 | 355 | 147 | 195 | 223 | 327 | 314 | |
Yeast GFP Assignment
Protein Abundance
| Screen | WT1 | WT2 | WT3 | RAP60 | RAP140 | RAP220 | RAP300 | RAP380 | RAP460 | RAP540 | RAP620 | RAP700 | HU80 | HU120 | HU160 | rpd3Δ_1 | rpd3Δ_2 | rpd3Δ_3 | AF100 | AF140 | AF180 |
|---|---|---|---|---|---|---|---|---|---|---|---|---|---|---|---|---|---|---|---|---|---|
| Mean Cell GFP Intensity (1e-4) | 5.5 | 5.5 | 6.1 | 6.2 | 7.3 | 5.4 | 6.9 | – | 5.1 | 5.5 | 5.2 | 4.9 | 6.8 | 6.3 | 6.5 | 6.3 | 6.5 | 6.5 | 5.5 | 5.7 | 5.6 |
| Std Deviation (1e-4) | 1.2 | 1.3 | 1.4 | 2.2 | 1.8 | 1.3 | 1.7 | – | 1.1 | 1.6 | 1.5 | 1.1 | 1.6 | 1.7 | 2.1 | 1.3 | 1.6 | 1.6 | 1.3 | 1.7 | 1.7 |
| Intensity Change (Log2) | – | – | – | 0.03 | 0.26 | -0.18 | 0.17 | – | -0.25 | -0.14 | -0.22 | -0.33 | 0.15 | 0.06 | 0.08 | 0.04 | 0.1 | 0.09 | -0.15 | -0.1 | -0.13 |
Localization Change
| Localization | RAP60 | RAP140 | RAP220 | RAP300 | RAP380 | RAP460 | RAP540 | RAP620 | RAP700 | HU80 | HU120 | HU160 | rpd3Δ_1 | rpd3Δ_2 | rpd3Δ_3 |
|---|---|---|---|---|---|---|---|---|---|---|---|---|---|---|---|
| Cortical Patches | 0 | 0 | 0 | 0 | – | 0 | 0 | 0 | 0 | 0 | 3.9 | 3.4 | 0 | 0 | 0 |
| Bud | 0 | 0 | 0 | 0 | – | 0 | 0 | 3.3 | 0 | 0 | 2.8 | 0 | 0 | 0 | 0 |
| Bud Neck | 0 | 0 | 0 | 0 | – | 0 | 0 | 0 | 0 | 0 | 0 | 0 | 0 | 0 | 0 |
| Bud Site | 0 | 0 | 0 | 0 | – | 0 | 0 | 0 | 0 | 0 | 0 | 0 | 0 | 0 | 0 |
| Cell Periphery | 0 | 0 | 0 | 0 | – | 0 | 0 | 0 | 0 | 0 | 2.7 | 3.0 | 0 | 0 | 0 |
| Cytoplasm | 1.7 | 1.4 | 1.1 | 0.1 | – | 0 | 1.2 | 0.9 | 1.4 | -3.1 | -2.7 | -2.8 | -5.1 | -0.1 | -4.0 |
| Endoplasmic Reticulum | 0 | 0 | 0 | 0 | – | 0.5 | 0 | 0 | 0 | 2.8 | 0 | 0.2 | 1.0 | 0.3 | 1.0 |
| Endosome | 0 | 0 | 0 | 0 | – | 0 | 0 | 0 | 0 | 0 | 2.8 | 0 | 0 | 0 | 0 |
| Golgi | 0 | 0 | 0 | 0 | – | 0 | 0 | 0 | 0 | 0 | 0 | 0 | 0 | 0 | 0 |
| Mitochondria | 0 | 0 | 0 | 0 | – | 0 | 0 | 3.0 | 0 | 0 | 0 | 0 | 0 | 0 | 0 |
| Nucleus | 0 | 0 | 0 | 0 | – | 0 | 0 | 0 | 0 | 0 | 0 | 0 | 0 | 0 | 0 |
| Nuclear Periphery | 0 | 0 | 0 | 0 | – | 0 | 0 | 0 | 0 | 0 | 0 | 0 | 0 | 0 | 0 |
| Nucleolus | 0 | 0 | 0 | 0 | – | 0 | 0 | 0 | 0 | 0 | 0 | 0 | 0 | 0 | 0 |
| Peroxisomes | 0 | 0 | 0 | 0 | – | 0 | 0 | 0 | 0 | 0 | 0 | 0 | 0 | 0 | 0 |
| SpindlePole | 0 | 0 | 0 | 0 | – | 0 | 0 | 0 | 0 | 0 | 2.1 | 1.9 | 0 | 0 | 0 |
| Vacuole | -1.0 | 2.0 | -2.2 | -0.2 | – | -2.8 | -2.4 | -2.6 | -2.0 | -2.5 | 0 | -3.0 | 5.7 | 2.9 | 4.7 |
External localization resources
Images






























Protein Concentration and Protein Localization Data
| R1 | R2 | R3 | ||||||||||||||||
|---|---|---|---|---|---|---|---|---|---|---|---|---|---|---|---|---|---|---|
| G1 Pre-START | G1 Post-START | S/G2 | Metaphase | Anaphase | Telophase | G1 Pre-START | G1 Post-START | S/G2 | Metaphase | Anaphase | Telophase | G1 Pre-START | G1 Post-START | S/G2 | Metaphase | Anaphase | Telophase | |
| Concentration | -0.6323 | 0.369 | 0.2292 | -0.0188 | -0.2333 | 0.1224 | 1.9222 | 2.1634 | 2.4998 | 2.4874 | 1.8249 | 2.2861 | 2.2226 | 3.4744 | 3.2069 | 3.1371 | 2.991 | 3.017 |
| Actin | 0.0138 | 0.0015 | 0.0083 | 0.0013 | 0.0005 | 0.004 | 0.0302 | 0.0038 | 0.0143 | 0 | 0.0027 | 0.002 | 0.0162 | 0.0006 | 0.0171 | 0 | 0.0211 | 0.0004 |
| Bud | 0.0013 | 0.0015 | 0.002 | 0.0009 | 0.0008 | 0.0006 | 0.0011 | 0.0021 | 0.0046 | 0.0003 | 0.0003 | 0.0007 | 0.0014 | 0.0014 | 0.0008 | 0.0005 | 0.0019 | 0.0025 |
| Bud Neck | 0.002 | 0.0023 | 0.0029 | 0.0022 | 0.0015 | 0.0066 | 0.0041 | 0.0075 | 0.004 | 0.0017 | 0.0031 | 0.0145 | 0.0016 | 0.0022 | 0.0068 | 0.0011 | 0.0018 | 0.0072 |
| Bud Periphery | 0.0019 | 0.0028 | 0.0055 | 0.0017 | 0.0008 | 0.0016 | 0.0025 | 0.0034 | 0.0061 | 0.0007 | 0.0004 | 0.002 | 0.0044 | 0.0031 | 0.0019 | 0.0007 | 0.0077 | 0.0043 |
| Bud Site | 0.0054 | 0.0054 | 0.003 | 0.0012 | 0.0065 | 0.0012 | 0.0097 | 0.02 | 0.0231 | 0.0014 | 0.0017 | 0.0021 | 0.004 | 0.0114 | 0.0048 | 0.0012 | 0.0029 | 0.0021 |
| Cell Periphery | 0.0025 | 0.0027 | 0.0017 | 0.0021 | 0.001 | 0.003 | 0.0055 | 0.0054 | 0.0026 | 0.0036 | 0.0009 | 0.0053 | 0.0026 | 0.004 | 0.003 | 0.0007 | 0.0017 | 0.0033 |
| Cytoplasm | 0.1183 | 0.1361 | 0.0723 | 0.0431 | 0.0467 | 0.0826 | 0.1886 | 0.1903 | 0.1465 | 0.0551 | 0.0679 | 0.1471 | 0.1179 | 0.1652 | 0.115 | 0.0641 | 0.027 | 0.1221 |
| Cytoplasmic Foci | 0.0838 | 0.054 | 0.0639 | 0.0704 | 0.0478 | 0.0418 | 0.0905 | 0.0445 | 0.0697 | 0.0125 | 0.0502 | 0.0391 | 0.075 | 0.0329 | 0.054 | 0.0547 | 0.0271 | 0.0334 |
| Eisosomes | 0.0007 | 0.0001 | 0.0002 | 0 | 0.0001 | 0.0001 | 0.0005 | 0.0001 | 0.0001 | 0 | 0.0001 | 0 | 0.0004 | 0 | 0.0001 | 0 | 0.0002 | 0 |
| Endoplasmic Reticulum | 0.0167 | 0.0108 | 0.0164 | 0.0068 | 0.0032 | 0.0091 | 0.029 | 0.0172 | 0.0154 | 0.006 | 0.009 | 0.0138 | 0.0146 | 0.0201 | 0.01 | 0.0039 | 0.0067 | 0.0095 |
| Endosome | 0.3297 | 0.2619 | 0.3727 | 0.3363 | 0.3452 | 0.2731 | 0.2562 | 0.1893 | 0.3057 | 0.2769 | 0.4395 | 0.1622 | 0.2669 | 0.1668 | 0.2997 | 0.3804 | 0.3571 | 0.2022 |
| Golgi | 0.0186 | 0.0063 | 0.0134 | 0.0163 | 0.0231 | 0.0107 | 0.0272 | 0.0146 | 0.0224 | 0.01 | 0.0138 | 0.0105 | 0.0133 | 0.0063 | 0.0117 | 0.0105 | 0.0122 | 0.0068 |
| Lipid Particles | 0.0281 | 0.0101 | 0.0198 | 0.0072 | 0.0093 | 0.009 | 0.042 | 0.0092 | 0.0211 | 0.015 | 0.0351 | 0.0104 | 0.0236 | 0.0135 | 0.0184 | 0.0057 | 0.0197 | 0.0082 |
| Mitochondria | 0.0128 | 0.0073 | 0.0148 | 0.0058 | 0.0138 | 0.0126 | 0.0157 | 0.002 | 0.0136 | 0.0017 | 0.001 | 0.0139 | 0.0097 | 0.0016 | 0.0207 | 0.0081 | 0.0072 | 0.0065 |
| None | 0.0915 | 0.08 | 0.0482 | 0.0388 | 0.0719 | 0.05 | 0.0705 | 0.0569 | 0.0394 | 0.0004 | 0.0052 | 0.0366 | 0.182 | 0.0913 | 0.0509 | 0.0349 | 0.027 | 0.0632 |
| Nuclear Periphery | 0.0132 | 0.0047 | 0.0053 | 0.0138 | 0.0017 | 0.0061 | 0.008 | 0.0042 | 0.0065 | 0.0025 | 0.0111 | 0.0041 | 0.0127 | 0.0064 | 0.0037 | 0.0038 | 0.0035 | 0.0033 |
| Nucleolus | 0.0021 | 0.0014 | 0.0014 | 0.0011 | 0.0015 | 0.0011 | 0.0013 | 0.0014 | 0.001 | 0.001 | 0.0024 | 0.002 | 0.0046 | 0.0019 | 0.0016 | 0.0015 | 0.0013 | 0.0012 |
| Nucleus | 0.0081 | 0.0044 | 0.0031 | 0.0035 | 0.0024 | 0.0047 | 0.0047 | 0.0048 | 0.0043 | 0.0018 | 0.0176 | 0.0085 | 0.0062 | 0.0074 | 0.0031 | 0.0032 | 0.0028 | 0.0043 |
| Peroxisomes | 0.004 | 0.0013 | 0.0069 | 0.0019 | 0.003 | 0.0022 | 0.0193 | 0.0007 | 0.0081 | 0.0002 | 0.0007 | 0.0034 | 0.0096 | 0.0007 | 0.003 | 0.0021 | 0.006 | 0.0011 |
| Punctate Nuclear | 0.0088 | 0.001 | 0.0042 | 0.0008 | 0.0005 | 0.0013 | 0.0071 | 0.0007 | 0.0028 | 0.0001 | 0.0108 | 0.0024 | 0.0108 | 0.0008 | 0.0015 | 0.0028 | 0.0018 | 0.0004 |
| Vacuole | 0.2132 | 0.3731 | 0.3075 | 0.4004 | 0.3947 | 0.4467 | 0.1761 | 0.4058 | 0.2697 | 0.5865 | 0.3093 | 0.5042 | 0.2029 | 0.4458 | 0.3436 | 0.3919 | 0.4172 | 0.4864 |
| Vacuole Periphery | 0.0232 | 0.0313 | 0.0266 | 0.0446 | 0.024 | 0.0319 | 0.0101 | 0.0164 | 0.0192 | 0.0226 | 0.0173 | 0.0151 | 0.0198 | 0.0166 | 0.0284 | 0.0283 | 0.046 | 0.0317 |
Sequencing Data
| R1 | R2 | |||||||||
|---|---|---|---|---|---|---|---|---|---|---|
| G1 Post-START | S/G2 | Metaphase | Anaphase | Telophase | G1 Post-START | S/G2 | Metaphase | Anaphase | Telophase | |
| Gene Expression | 223.1213 | 169.8499 | 94.8161 | 89.265 | 245.2155 | 137.6314 | 244.2104 | 161.1037 | 79.9317 | 262.2667 |
| Translational Efficiency | 1.3385 | 1.3036 | 0.7201 | 0.364 | 1.2125 | 1.5549 | 0.8195 | 0.5637 | 0.8851 | 0.8752 |
Hit Data
| Dataset | Hit |
|---|---|
| Protein Concentration | ✔ |
| Protein Localization | ✘ |
| Gene Expression | ✘ |
| Translational Efficiency | ✘ |
Endocytosis
| Temp | Actin Patch (Sac6-tdTomato) | Cortical Patch (Sla1-GFP) | Late Endosome (Snf7-GFP) | Vacuole (Vph1-GFP) |
|---|---|---|---|---|
| 37℃ | ||||
| RT |
Cell Cycle Omics
CYCLoPs (Srl1-GFP)
| Gene / Allele | Actin Patch (Sac6-tdTomato) | Cortical Patch (Sla1-GFP) | Late Endosome (Snf7-GFP) | Vacuole (Sac6-tdTomato) |
|---|
| Gene | Images |
|---|
| Gene | Images |
|---|
Images are not yet available
Images are not yet available